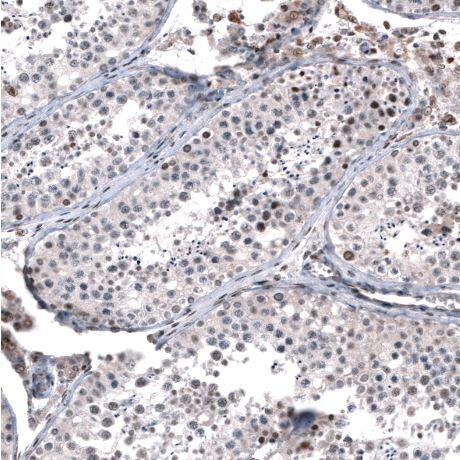
GLI-1 Antibody (CL12191)

GLI-1 Antibody (CL12193) - BSA Free
Novus Biologicals, part of Bio-Techne | Catalog # NBP3-15131

![Immunocytochemistry/Immunofluorescence: GLI-1 Antibody (CL12191) [NBP3-15131] - GLI-1 Antibody (CL12191)](https://resources.bio-techne.com/images/products/antibody/nbp3-15131_mouse-gli-1-mab-cl12191-immunocytochemistry-immunofluorescence-41020238465..jpg)
Conjugate
Catalog #
Forumulation
Catalog #
Key Product Details
Species Reactivity
Validated:
Human, Mouse
Predicted:
Rat (95%). Backed by our 100% Guarantee.
Applications
Immunohistochemistry, Immunohistochemistry-Paraffin, Immunocytochemistry/ Immunofluorescence
Label
Unconjugated
Antibody Source
Monoclonal Mouse IgG2B Clone # CL12193
Format
BSA Free
Concentration
1 mg/ml
Product Specifications
Immunogen
This antibody was developed using a synthetic peptide derived from P08151, with the exact immunogen sequence remaining proprietary.
Clonality
Monoclonal
Host
Mouse
Isotype
IgG2B
Scientific Data Images for GLI-1 Antibody (CL12193) - BSA Free
Immunocytochemistry/Immunofluorescence: GLI-1 Antibody (CL12191) [NBP3-15131] -
Immunocytochemistry/Immunofluorescence: GLI-1 Antibody (CL12191) [NBP3-15131] -Staining of RH-30 cells using the Anti-GLI1 monoclonal antibody, showing specific staining in the nucleoplasm and cytosol in green. Microtubule- and nuclear probes are visualized in red and blue, respectively (where available).Immunohistochemistry-Paraffin-GLI-1 Antibody (CL12191)-NBP3-15131-
Immunohistochemistry-Paraffin-GLI-1 Antibody (CL12191)-NBP3-15131- Staining of Human cerebellum shows moderate nuclear positivity in Purkinje cells, as well as neurons in molecular layer.Immunohistochemistry-Paraffin-GLI-1 Antibody (CL12191)-NBP3-15131-
Immunohistochemistry-Paraffin-GLI-1 Antibody (CL12191)-NBP3-15131-Staining of mouse cerebellum shows strong nuclear positivity in Purkinje cells.Applications for GLI-1 Antibody (CL12193) - BSA Free
Application
Recommended Usage
Immunocytochemistry/ Immunofluorescence
2-10 ug/ml
Immunohistochemistry
1:500 - 1:1000
Immunohistochemistry-Paraffin
1:500 - 1:1000
Application Notes
For IHC-Paraffin, HIER pH 6 retrieval is recommended. ICC/IF Fixation Permeabilization: Use PFA/Triton X-100.
Formulation, Preparation, and Storage
Purification
Protein A purified
Formulation
PBS (pH 7.2) and 40% Glycerol
Format
BSA Free
Preservative
0.02% Sodium Azide
Concentration
1 mg/ml
Shipping
The product is shipped with polar packs. Upon receipt, store it immediately at the temperature recommended below.
Stability & Storage
Store at 4C short term. Aliquot and store at -20C long term. Avoid freeze-thaw cycles.
Background: GLI-1
Long Name
Glioma-Associated Oncogene Homolog 1 [Zinc Finger Protein]
Alternate Names
GLI1
Gene Symbol
GLI1
Additional GLI-1 Products
Product Documents for GLI-1 Antibody (CL12193) - BSA Free
Product Specific Notices for GLI-1 Antibody (CL12193) - BSA Free
This product is for research use only and is not approved for use in humans or in clinical diagnosis. Primary Antibodies are guaranteed for 1 year from date of receipt.
Loading...
Loading...
Loading...
Loading...